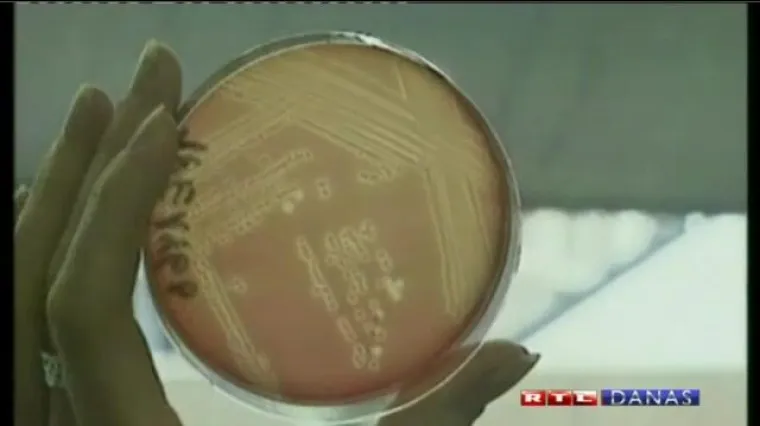
Opasna bakterija ubila tri osobe

Opasna bakterija ubila tri osobe
BERLIN - Njemačku je poharao po život opasan oblik bakterije Escherichije coli. Smrtonosnom bakterijom zaraženo je više od 400 ljudi, a tri su osobe preminule od posljedica zaraze.
Prva je osoba 83-godišnja starica koja je od simptoma zaraze patila punih 10 dana prije nego što je preminula, dok je druga osoba 25-godišnja djevojka. Treća žrtva je 80-godišnjakinja iz pokrajine Schleswig-Holstein.
Bakterija EHEC, odnosno posebni oblik bakterije Escherichije coli, stvara otrove koji mogu uzrokovati zatajenje bubrega, grčeve u trbuhu, dijareju i anemiju.
Pretpostavlja se da se zaraza proširila putem kontaminiranog povrća, ali je u slučaju Njemačke neobično to što je zarazila velik broj odraslih osoba, a inače je karakteristična za djecu.














